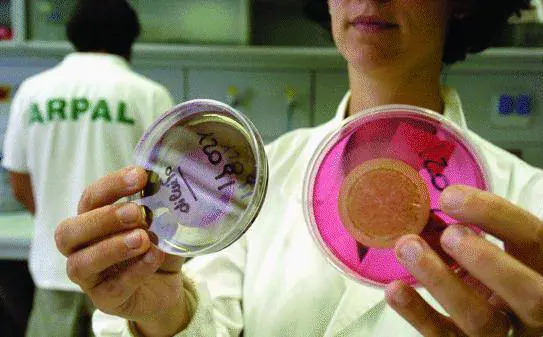
«Le macchie gialle in mare causate dai pollini»

Il pericolo alghe, per ora, sembra scongiurato. Domenica alcune macchie gialle sono state viste in mare sulla costa di Levante. I genovesi sulle spiagge hanno subito dato lallarme e ieri lArpal ha chiarito laccaduto. «Lesame microscopico dei campioni di acqua marina ha evidenziato la presenza massiva di polline di Pinaceae - spiega lAgenzia regionale per la protezione dellambiente in una nota- Il vento trasporta in mare tali sostanze naturali, il gioco delle correnti e della risacca ne favorisce laccumulo in strisce e chiazze grigio-giallastre».
I campioni sono stati prelevati fra il 16 e il 20 aprile in diversi punti del Mar Ligure fra Rapallo e Arenzano dalla Capitaneria del Porto. «Il polline delle Pinaceae è altamente impermeabile e ha una forma caratteristica, con due sacche aerifere (una sorta di paracadute) che gli permette di volare anche a grandi distanze - spiegano gli esperti-. Il nostro bollettino pollinico segnala un aumento di questi pollini soprattutto nel Levante».
«Il Mar Ligure rassicura Bruno Soracco, direttore generale dellArpal è il più controllato dItalia: dal primo aprile al trenta settembre effettuiamo almeno un campionamento ogni quindici giorni su oltre quattrocento punti di misura. Siamo stati allertati su una possibile esplosione di mucillaggine nel corso della stagione estiva, e manteniamo alta la guardia nei confronti dellalga invisibile Ostreopsis, pronti a dare lallarme ai primi segnali di pericolo. Ma come ulteriore garanzia sulla qualità delle nostre acque vorrei ricordare che i limiti imposti dalla legge italiana sono molto più restrittivi di quelli adottati da Paesi limitrofi.
